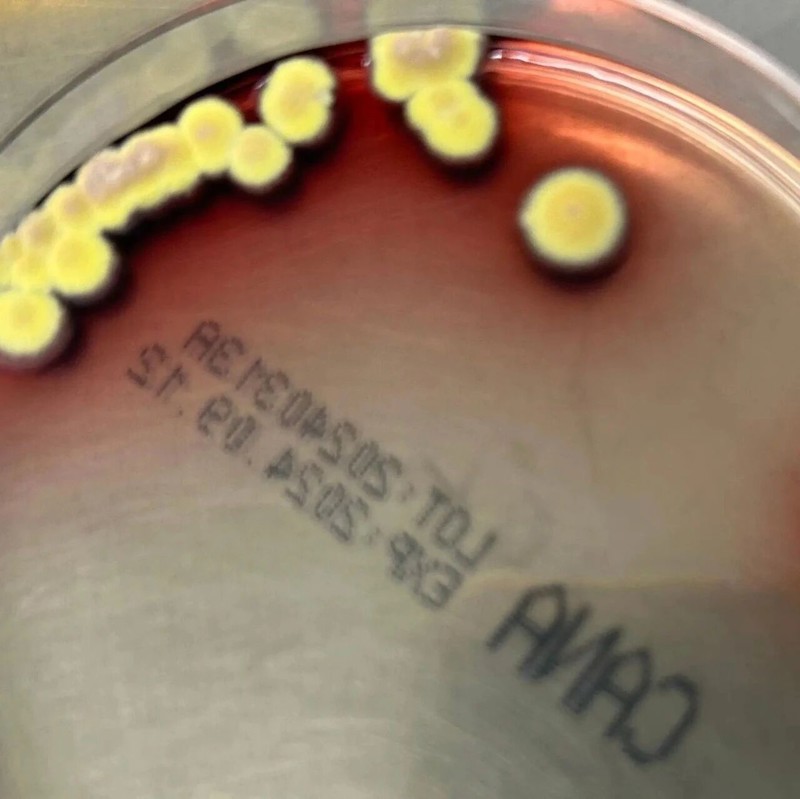

临床案例
-

中枢神经系统特殊菌感染的诊疗思考
2025-10-15 -

迷雾中的“套索”:一例非典型套细胞淋巴瘤的破局诊断
2025-09-25 -

病例报告:新型隐球菌致血流感染合并肺炎的临床分析
2025-09-25 -

血常规复检“揪出”罕见白血病:一例毛细胞白血病的发现之旅
2025-09-25 -

检验引导诊断:显微镜下破解不明原因骨痛的“真凶”—前列腺癌骨转移
2025-09-25 -

从1例假阳性样本探讨异嗜性抗体对免疫测定的干扰
2025-09-25 -

胎儿母体输血综合征临床案例分析
2025-09-25 -

一份特殊“溶血”标本的让步检验
2025-09-25 -

外周血中,易被新手忽略的颗粒淋巴细胞
2025-09-25 -

谁吃了我的血细胞?
2025-09-25 -

4岁男童反复感染:竟揪出罕见病“X-连锁高IgM综合征”
2025-09-25 -

凝血功能异常谜团:当纤维蛋白原结果“言行不一”时
2025-09-25 -

九旬老者TRUST由阴转阳:非梅毒螺旋体实验的“陷阱”
2025-09-25 -

甲功“过山车”?警惕PD-1治疗引发的甲状腺炎
2025-09-25 -

血糖正常,尿糖3+:这不是误差,是疗效!
2025-09-25 -

深“水”察鱼,追根究“核——一例免疫力低下老年患者肺外结核感染
2025-09-25 -

一例RDT假阴性的复发卵形疟
2025-09-25 -
皮肤感染马尔尼菲蓝状菌1例案例分析及文献复习
2025-09-25 -

揪出肿瘤背后的“隐形杀手”:噬血细胞综合征
2025-09-25 -

“免疫怪病”变血癌,没把这个指标当回事?
2025-09-25




